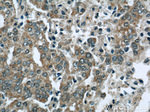
EFEMP2 Antibody in Immunohistochemistry (Paraffin) (IHC (P))
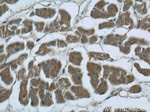
EFEMP2 Antibody in Immunohistochemistry (Paraffin) (IHC (P))

Search
Proteintech
EFEMP2 Polyclonal Antibody
{{$productOrderCtrl.translations['antibody.pdp.commerceCard.promotion.promotions']}}
{{$productOrderCtrl.translations['antibody.pdp.commerceCard.promotion.viewpromo']}}
{{$productOrderCtrl.translations['antibody.pdp.commerceCard.promotion.promocode']}}: {{promo.promoCode}} {{promo.promoTitle}} {{promo.promoDescription}}. {{$productOrderCtrl.translations['antibody.pdp.commerceCard.promotion.learnmore']}}
产品信息
12004-1-AP
种属反应
宿主/亚型
分类
类型
抗原
偶联物
形式
浓度
规格
纯化类型
保存液
内含物
保存条件
运输条件
产品详细信息
Immunogen sequence: PGSYQCTCP DGYRKIGPEC VDIDECRYRY CQHRCVNLPG SFRCQCEPGF QLGPNNRSCV DVNECDMGAP CEQRCFNSYG TFLCRCHQGY ELHRDGFSCS DIDECSYSSY LCQYRCVNEP GRFSCHCPQG YQLLATRLCQ DIDECESGAH QCSEAQTCVN FHGGYRCVDT NRCVEPYIQV SENRCLCPAS NPLCREQPSS IVHRYMTITS ERSVPADVFQ IQATSVYPGA YNAFQIRAGN SQGDFYIRQI NNVSAMLVLA RPVTGPREYV LDLEMVTMNS LMSYRASSVL RLTVFVGAYT F (144-443 aa encoded by BC010456)
靶标信息
EFEMP2 have been found to contain variations of the epidermal growth factor (EGF) domain and have been implicated in functions as diverse as blood coagulation, activation of complement and determination of cell fate during development. The protein contains four EGF2 domains and six calcium-binding EGF2 domains. This protein is necessary for elastic fiber formation and connective tissue development.
仅用于科研。不用于诊断过程。未经明确授权不得转售。
生物信息学
蛋白别名: EFEMP2; EGF containing fibulin like extracellular matrix protein 2; EGF-containing fibulin-like extracellular matrix protein 2; EGF-containing fibulin-like extracellular matrix protein 2 (Efemp2); FIBL-4; fibulin 4; Fibulin-4; Fibulin4; mutant p53 binding protein 1; Mutant p53-binding protein 1; Protein UPH1; unnamed protein product
基因别名: 0610011K11Rik; ARCL1B; EFEMP2; FBLN4; MBP1; UNQ200/PRO226; UPH1
UniProt ID: (Human) O95967, (Mouse) Q9WVJ9
Entrez Gene ID: (Human) 30008, (Mouse) 58859